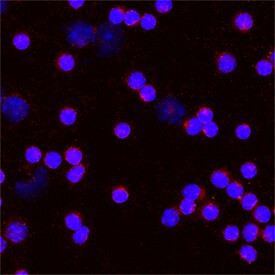
CD275 (B7-H2) Antibody in Immunocytochemistry (ICC/IF)

Search
Invitrogen
CD275 (B7-H2) Polyclonal Antibody
{{$productOrderCtrl.translations['antibody.pdp.commerceCard.promotion.promotions']}}
{{$productOrderCtrl.translations['antibody.pdp.commerceCard.promotion.viewpromo']}}
{{$productOrderCtrl.translations['antibody.pdp.commerceCard.promotion.promocode']}}: {{promo.promoCode}} {{promo.promoTitle}} {{promo.promoDescription}}. {{$productOrderCtrl.translations['antibody.pdp.commerceCard.promotion.learnmore']}}
图: 1 / 1
CD275 (B7-H2) Antibody (PA5-47161) in ICC/IF

Please note: We are reviewing Western blot images included in the antibody testing data in our catalog, including those provided by third parties. Unless expressly labeled or annotated as “raw-unedited”, Western blot images included in the antibody testing data in our catalog may have been edited, optimized or otherwise adjusted for presentation.
产品信息
PA5-47161
种属反应
已发表种属
宿主/亚型
分类
类型
抗原
偶联物
形式
浓度
规格
纯化类型
保存液
内含物
保存条件
运输条件
RRID
产品详细信息
In direct ELISAs and Western blots, less than 2% cross-reactivity with recombinant human (rh) B7-H2, recombinant mouse (rm) B7-1, rhB7-1, and rmB7-2 is observed.
Reconstitute at 0.2 mg/mL in sterile PBS.
靶标信息
Inducible co-stimulator ligand (ICOSL) is a specific ligand on antigen-presenting cells and cells of the peripheral tissue that binds to the inducible co-stimulator receptor (ICOS). ICOS belongs to the CD28/CD152 receptor family that regulates T-cell activation and function. ICOSL is expressed on monocytes, dendritic cells and B cells and can be induced by inflammatory stimuli in peripheral tissue. Binding to ICOSL delivers a co-stimulatory signal for T cell proliferation and cytokine secretion.
仅用于科研。不用于诊断过程。未经明确授权不得转售。
生物信息学
蛋白别名: B7 homolog 2; B7-H2; B7-like protein Gl50; B7-related protein 1; B7RP-1; CD275; ICOS ligand; LICOS
基因别名: AU044799; B7-H2; B7h; B7h2; B7RP-1; B7rp1; BG071784; GI50; GL50; GL50-B; ICOS-L; Icosl; Icoslg; LICOS; Ly115l; mKIAA0653
UniProt ID: (Mouse) Q9JHJ8
Entrez Gene ID: (Mouse) 50723